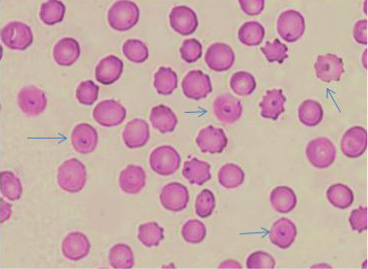

Advances in Animal and Veterinary Sciences
Research Article
Adv. Anim. Vet. Sci. 8(3): 290-296.
Figure 1
Piroplasmic form of T. annulata using Giemsa staining method.
Figure 2
Amplified products of 30 KD a major merozoite surface antigen gene of rDNA for T. annulata. Lane L, molecular size marker (100 base-pair ladder); lanes1: 10 positive samples at 785bp; Lane Neg: negative control, Lane Pos: positive control.